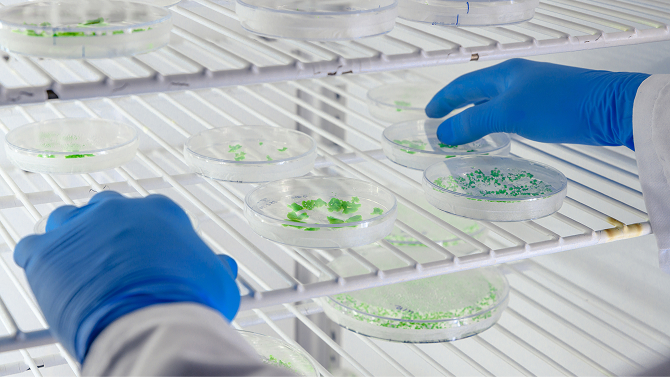

アンケート
現状把握をするため、
アンケートを送付
頂きます。

業界の最新情報は知りたいが専門性が高く、情報収集が大変

いろいろな検査装置が
ありすぎて
わからない

再生医療の実用化が進む今、無菌性をすばやく確認したいというニーズが急増しています。
しかし、従来の培養法による
無菌性確認では14日間を要するため、現場では大きな課題となっています。
そのため、いまの微生物検査には
目的に応じて『迅速法を標準化する』ことが求められています。
| 迅速法 | 従来の培養法 | |
|---|---|---|
| メリット | ||
| メリット |
|
|
| デメリット | ||
| デメリット |
|
|

再生医療の治療薬製造中間工程品
である細胞培養液サンプルに対して、
従来の培養法と迅速法の検査法を徹底比較しました。
スクリーンショットで、画像を保存できます。
サイトに戻って、各サービスの詳細を確認してみましょう。

| 原理の比較 | ||||||
|---|---|---|---|---|---|---|
| 原理 | 培養法 | 培養組合せ迅速法 (CO₂検出法) |
AFI法① | AFI法② | ATP法 | NAT法(PCR) |
| 無菌性確 認試験法 概要 |
TSB/FTMで20-35℃培養液の濁りで判別 | 専用培地で20-35℃培養微生物の代謝産物の増加を検出 | フローサイトメトリー×固相サイトメトリーにより生菌検出 | 前培養48時間+AFI法① | 前培養48時間の前後で ATPの発光量を比較 |
前培養48時間の前後で 微生物の遺伝子量を比較 |
| 検出対象 | 培養で増殖できる菌による濁り具合 | 培養で増殖できる菌の代謝産物 | 培養できない菌を含む全生菌(細菌・真菌)を直接顕微鏡観察 | 培養で増殖できる菌の全生菌(細菌・真菌)を直接顕微鏡観察 | 培養で増殖できる菌の前培養前後のサンプル中の全ATPの発光量の差分 | 培養で増殖できる菌の前培養前後のサンプル中の全微生物の遺伝子量の差分 |
| 検査時間 (前培養時間含む) |
14日間 | 5日間 | 32分 (前処理15分+測定17分) |
前培養48時間 +測定32分 |
前培養48時間 +測定3時間 |
前培養48時間 +測定4時間 |
| 対象微生物の 検出下限 【理論値】 |
1CFU/mL | 1CFU/mL | 10CFU/mL | 1CFU/mL | 1CFU/mL | 1CFU/mL |
| 優位ポイント | ・積み重ねられた実績 | ・培養法と同等の検出能と従来培養法より約9日間検査時間短縮 | ・検査時間32分 ・検査条件に依存しない ・全生菌を培養前に検出 ・真菌・細菌同時検出 ・微生物凝集塊可能 ・検出した生菌回収可能 |
・培養法と同等の検出能と従来培養法より約12日間検査時間短縮 ・真菌・細菌同時検出 ・微生物観察可能 ・検出した生菌回収可能 |
・培養法と同等の検出能と従来培養法より約12日間検査時間短縮 | ・培養法と同等の検出能と従来培養法より約12日間検査時間短縮 |
| 多検体同 時検出 |
||||||
| 原理的課題 | ・『 培養条件に合わない微生物 』 の見逃し ・投与前判断不可 |
・『 培養条件に合わない微生物 』 の見逃し ・投与前判断不可 |
・理論上の検出下限は1オーダー低い | ・『 培養条件に合わない微生物 』 の見逃し ・前培養期間中の投薬の変化は検知できない |
・『 培養条件に合わない微生物 』 の見逃し ・前培養期間中の投薬の変化は検知できない ・前培養を行わない場合は細胞由来ATPを誤検知 |
・『 培養条件に合わない微生物 』 の見逃し ・前培養期間中の投薬の変化は検知できない ・前培養を行わない場合は死菌遺伝子を誤検知 |
| 1サンプルの 無菌確認に 必要な試験回数 |
TSB/FTMで 2試験 |
嫌気・好気条件別で 2試験 |
全生菌を1試験 | 嫌気・好気 条件別で2試験 |
嫌気・好気条件、 前培養前後別で4試験 |
嫌気・好気条件、 前培養前後、 細菌・真菌別で8試験 |
| 1サンプルに 必要なランニング コスト |
低 (2試験分の培地) |
中 (2試験分の培養ボトル) |
低 (1000円前後) |
中 (2試験分のバッファ) |
やや高 (4試験分の試薬) |
高 (8試験分の試薬) |
| 検出した微生物 の生菌回収 |
||||||
| 検出見逃し率 (培養できない菌と ポアソン分布の影響) 【理論値】 |
一般環境中の全生菌の 98.1%を見逃す |
一般環境中の全生菌の 98.1%を見逃す |
一般環境中の全生菌の 0.0045%を見逃す ※培養出来ない菌も 検出できるため |
一般環境中の全生菌の 98.1%を見逃す |
一般環境中の全生菌の 98.1%を見逃す |
一般環境中の全生菌の 98.1%を見逃す |
| 工程管理 運用適正 |
||||||
| 投与直前 検査可否 |
10CFU/mL |
培養増殖可能な菌のみ |
培養増殖可能な菌のみ |
培養増殖可能な菌のみ |
||
 前培養不要
前培養不要
 生菌を
生菌を
 菌体回収可能
菌体回収可能

 前培養不要
前培養不要
 生菌を
生菌を
 菌体回収可能
菌体回収可能





1時間以内に検査結果を取得できるため、 製品の安全性・品質担保を実現。
「知りたいタイミングで結果がわかる」出荷判断の意思決定を即時化。
独自の電極フィルタ技術「AMATAR™」で、生菌のみを分離・可視化。
AI画像解析が自動カウントまで担うため、再現性とスループットを両立。
非培養法の装置として先行して「 AOAC-PTM認証」を取得し、信頼性を実証。
データインティグリティの要件を満たし、信頼性の高い分析結果の提供が可能。
従来の試験法に対する非劣性や、測定対象サンプルに対する適合性を
ご確認のうえ、購入をご検討いただけるようご提案します。

現状把握をするため、
アンケートを送付
頂きます。

お客様が検査を希望する
サンプルを送付頂きます。

サンプルが弊社原理で測定可能かどうかを無償で確認させて
頂きます。

特性評価試験の結果を元に
お客様の採用条件(検収条件)をお伺いします。

採用条件を達成する為の
プロトコルを確立する有償試験をご提案し、実施いたします。

採用条件をクリアした
プロトコルの報告書をご提出しご説明を行います。

当社大阪事業所にて、
確立したプロトコルの
デモンストレーションを行い、再現性を確認して頂きます。

ご採用の意思表示を頂きましたら、納品までのスケジューリングを行い、ご希望の設置場所に据付納品いたします。
14日間の培養期間が長いため製品出荷前に無菌性を
判断できない